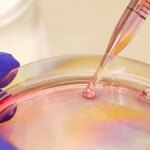
Boosting Immune System Memory Against Influenza

La deuxième pleine Lune d’août 2023, à la fois lune bleue et superlune, brille de mille feux au-dessus de la Terre alors que la Station spatiale internationale gravite à 260 milles au-dessus de l’océan Pacifique. Crédit : NASA
La robotique, la maintenance des laboratoires et la microbiologie étaient les principales priorités à bord du Station spatiale internationale (ISS) le mercredi 13 septembre. Les membres de l’équipage de l’Expédition 69 ont également eu du temps réservé aux opérations scientifiques de la Terre et aux tâches biomédicales.
Astrobee, l’assistant robotique volant libre de la taille d’un grille-pain et en forme de cube, a été activé aujourd’hui à l’intérieur du module de laboratoire Kibo. Les algorithmes écrits par les étudiants ont été reliés à l’avant-poste orbital pour contrôler les assistants robotiques, encourager la résolution de problèmes et promouvoir l’éducation spatiale. L’astronaute Satoshi Furukawa de JAXA (Japan Aerospace Exploration Agency) a surveillé les activités robotiques et a noté ses impressions pour examen sur le terrain.
S’élevant à 262 milles au-dessus de la côte nord-est de l’Australie, l’astronaute de l’ESA (Agence spatiale européenne) Andreas Mogensen a pris cette photo depuis la Station spatiale internationale. Le vaisseau spatial Cygnus de Northrop Grumman, amarré à la station depuis le 4 août 2023, est positionné à droite de l’image, affichant ses importants panneaux solaires en forme de cymbale. Crédit : NASA
Trois ingénieurs de vol ont travaillé en face de Kibo à l’intérieur du module de laboratoire Columbus pour finaliser la réorganisation des installations de recherche de l’ESA (Agence spatiale européenne). NASA L’ingénieur de vol Frank Rubio a lancé les travaux en transférant les supports de recherche et de fret dans des emplacements à bord du Columbus. Il a été rejoint dans la matinée par l’ingénieur de vol de l’ESA, Andreas Mogensen, qui l’a aidé à déplacer les racks d’avant en arrière.
L’ingénieur de vol de la NASA, Jasmin Moghbeli, a conclu les travaux dans l’après-midi en rétablissant le laboratoire Columbus dans sa configuration opérationnelle et en rangeant le matériel. Les travaux de Columbus ont été réalisés pour accueillir de nouveaux équipements d’exercice qui maintiendront les astronautes en bonne santé et en forme pendant les missions spatiales à long terme.
Les ingénieurs de vol de l’Expédition 69 (de gauche à droite) Jasmin Moghbeli et Frank Rubio, tous deux de la NASA, et Satoshi Furukawa de la JAXA (Japan Aerospace Exploration Agency) se joignent pour déjeuner à bord du module Unity de la Station spatiale internationale. Crédit : NASA
Mogensen a également étudié comment capturer les propriétés réfléchissantes de la Terre, également appelées albédo, en photographiant la Lune pendant des phases lunaires spécifiques. Les résultats pourraient fournir de nouvelles informations sur le climat de la Terre grâce aux instruments satellitaires. Moghbeli a prélevé son échantillon de sang en fin de journée pour un test de glycémie dans le cadre de l’étude Vascular Aging qui surveille les symptômes de vieillissement accéléré qui surviennent dans les artères des astronautes.
Roscosmos Le cosmonaute Konstantin Borissov était de retour en service de microbiologie mercredi, collectant et stockant des échantillons de microbes provenant de surfaces à l’intérieur du service Zvezda et des modules scientifiques de Nauka. L’ingénieur de vol Dmitri Petelin a étudié la fermentation pour améliorer la conservation et la préparation des aliments dans l’espace. Le commandant Sergueï Prokopyev a continué à préparer le matériel à emballer à l’intérieur du vaisseau spatial Soyouz MS-23 qui le ramènera, lui, Petelin et Rubio, sur Terre fin septembre.